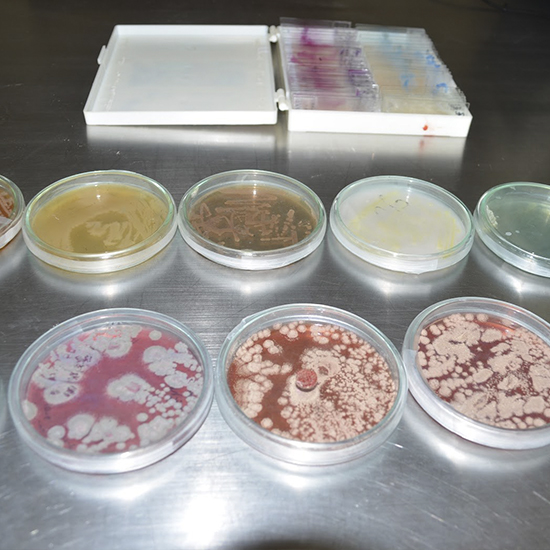
bioproducto mixto

Bioproducto mixto con microorganismos benéficos para su aplicación en cultivos hortícolas
Director del proyecto
Klever Ivan Granda Mora
Correo electrónico
klever.granda@unl.edu.ec
Línea de investigacion
Año
OBJETIVO GENERAL
Formular un bioproducto mixto con microorganismos benéficos para su aplicación en cultivos hortícolas.
OBJETIVOS ESPECÍFICOS
- Identificar microorganismos benéficos procedentes de diferentes agroecosistemas de la provincia de Loja.
- Evaluar las diferentes interacciones entre los microorganismos benéficos bajo condiciones controladas.
- Formular y validar el bioproducto para su aplicación en cultivos hortícolas a nivel de campo.
Grupo de Investigadores
- Klever Ivan Granda Mora
- Ángel Rolando Robles Carrión
- Ever Morales Avendaño
- Yadira Mercedes Collahuazo Reinoso
- Franco Guillen Guzmán
- Teodoro Feijoo Cisneros
- Yomara Fernández Cuenca
- Elizabeth Barba Ríos Cristina
- Bryan German Celi Alulima

